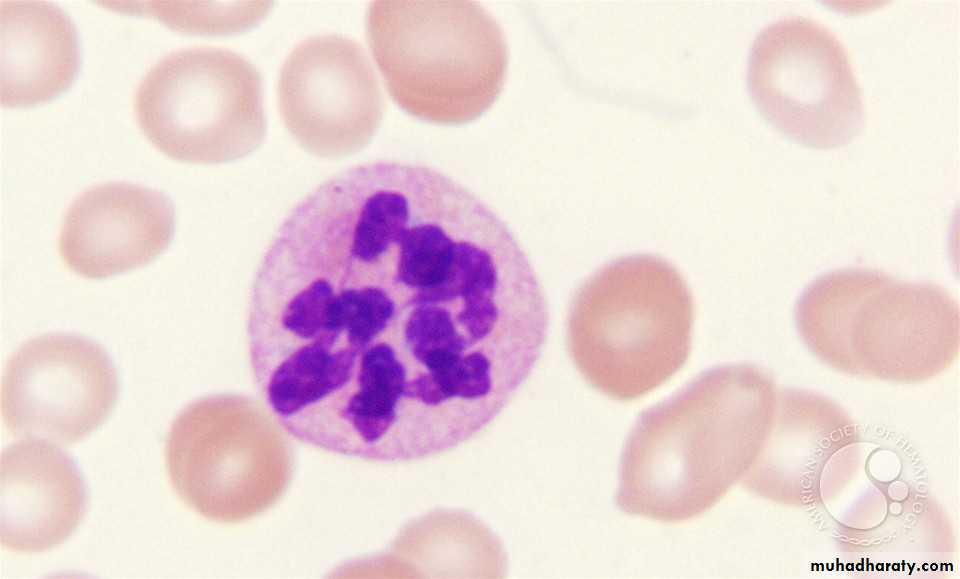
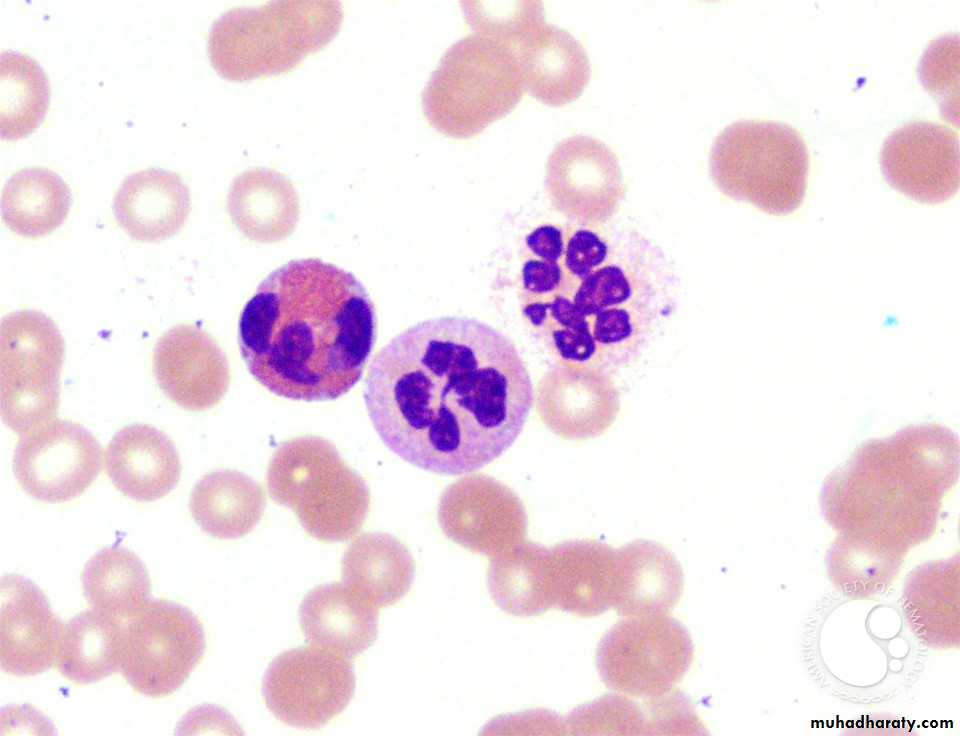
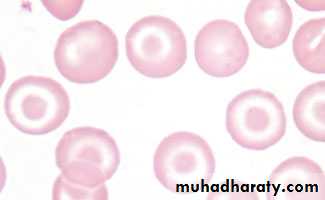
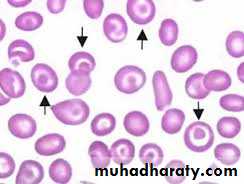
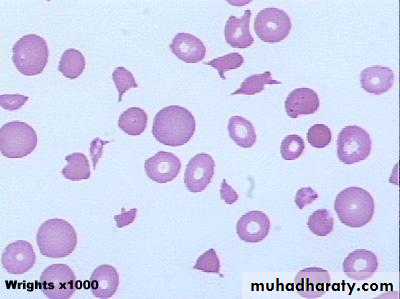

Pictures in hematology
د.محمد حارث الساعاتيPallor of conjunctiva anemia
Koilonychia ( spoon shape nail)
Causes :1. Iron deficiency anemia
2. Rarely amino acid deficiency
Angular chelitis
Cracks at the angle of the mouth commonly occur in iron deficiency anemiaJaundice
Jaundice with anemia occur in hemolytic anemia , it is usually mild (lemon colour ) & mainly indirect hyperbilirubinemia .Glossitis
Painful red beefy tongue ( with atrophy of papillae ) occur in1. Megaloblastic anemia
2. Iron deficiency anemia .
Oral candidiasis ( thrush)
White coated tongue due to candidiasis occur when there is low immunity due to HIV , diabetes , malignancy , steroid use , prolonged antibiotic therapy .Should be differentiated from food sticking on the tongue !
gingival hypertrophy
Causes :1. AML
2. Phenytoin
3. Rarely calcium channel blockers
Oral ulceration
Causes :1. Infection : viral , bacterial …
2. Traumatic
3. Autoimmune diseases : SLE , behcet disease ..
4. Malignancy
5. Inflammatory bowel diseases
6. Chemotherapy
Lymphadenopathy
Causes :Infective
• Bacterial: streptococcal, tuberculosis, brucellosis
• Viral: Epstein–Barr virus (EBV), human immunodeficiency
virus (HIV)
• Protozoal: toxoplasmosis
• Fungal: histoplasmosis, coccidioidomycosis
Neoplastic
• Primary: lymphomas, leukaemias
• Secondary: lung, breast, thyroid, stomach
Connective tissue disorders
• Rheumatoid arthritis
• Systemic lupus erythematosus (SLE)
Sarcoidosis
Amyloidosis
Drugs
• Phenytoin
lymphadenopathy
Bruises & petechia
Signs of bleeding tendencyCauses :
1. Thrombocytopenia
2. Platelets dysfunction
3. Coagulation defect ( mainly cause muscle & joint bleeding)
4. Side effects of drugs like heparin , warfarin & aspirin …
Hepatosplenomegally
Causes :1. Infections : malaria , brucellosis , kala azar, miliary TB…
2. Hematological diseases : thalassemia, myelofibrosis ..
3. Leukemias , lymphomas .
4. Amyloidosis
5. Glycogen storage diseases
* See macloid”s clinical examination
Bone marrow study
Include bone marrow aspiration & biopsyIndications:
1. Bicytopenia or pancytopenia( leukemia , aplastic anemia …)
2. Suspected lymphoproliferative & myeloproliferative disorders
3. dx. & staging of lymphoma
4. dx. Of multiple myeloma
5. Part of work up in pyrexia of unknown origin .
& many other indications .
Some drugs used in hematology
Iron sucrose ( venofir) :Used in iron deficiency anemia , given as slow IV infusion , may cause hypersensetivity reactions therefore testing dose before use is indicated
Doxorubicin ( adriamycin)
Part of many chemotherapeutic regimen including ALL , AML , LYMPHOMA , & other solid malignancies .Side effects: bone marrow suppression , stomatitis , vomiting , alopecia , cardiotoxicity
Therefore , assessment of cardiac function ( by ECHO study ) is indicated before starting it .
Risk factor of cardiotoxicity : elderly , preexisting heart diseases , use of other cardiotoxic agents & chest radiation .
The drug is photosensetive ( should be protected from light ) .
Doxorubicin
Methotrexate
Given in hematological malignancies , solid organ malignancies & other non malignant conditions like rheumatoid arthritis .Can be given intrathecally in ALL for CNS prophylaxis .
Side effects : vomiting , diarrhoea , mucositis , bone marrow suppression , liver fibrosis .
Cyclophosphamide ( endoxan)
Used in NHL , breast CA , lupus nephritis & other malignant diseases .Side effects : bone marrow supression , infertility , hemorrhagic cystitis .
Risk of hemorrhagic cystitis can be reduced by the use of mesna .
hydroxyurea
Used as cytoreductive agent in CML , essential thrombocythemia & in sickle cell disease.Role in sickle cell :
1. Increase Hb F
2. Decrease level of circulating leucocytes .
3. Increase RBC hydration
Thereby decrease sickling
Imatinib ( glivic)
Tyrosin kinase inhibitor , specific for abnormal BCR-ABL tyrosin kinase produced by philadelphia chromosome .Indications :
1. CML
2. ALL ( that is positive for Ph. Chromosome)
3. Hypereosinophilic syndrome
4. Gastrointestinal stromal tumours .
Side effects of imatinib:
1. Edema
2. Neutropenia
3. Muscle cramps
4. Rash
5. Left ventricular dysfunction & congestive heart failure & may cause QT prolongation .
6. Liver troxicity
7. teratogenic
Cigar shape cells in IDA
Hypersegmented neutrophil in megaloblastic anemia
Bite & blister cells in G6PD deficiency
Bite cells blister cellsspherocytes
Causes :1. Heriditary spherocytosis
2. Autoimmune hemolytic anemia
Deferentiated by coomb”s test ( + in AIHA)
TARGET CELLS
Causes :1. Thalassemia
2. Liver disease
RBC fragments ( shictocytes)
Causes:1. Hemolytic uremic syndrome
2. TTP
3. DIC
4. Malignant HT
5. Valve hemolysis
6. Sever eclampsia